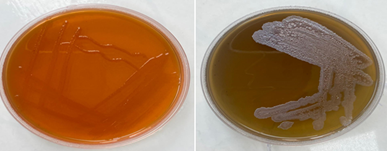

Research Article
Determining of Minimum Inhibitory Concentration (MIC) of ZnO NPs Preparation from of Aqueous Extract of Syzygium Aromaticum Against p. Aeruginosa Isolates
College of Biotechnology, Al-Nahrian University, Baghdad, Iraq.
*Corresponding Author: Ali S. Shati, College of Biotechnology, Al-Nahrian University, Baghdad, Iraq.
Citation: Shati A S, Risan M H. (2026). Determining of Minimum Inhibitory Concentration (MIC) of ZnO NPs Preparation from of Aqueous Extract of Syzygium Aromaticum Against p. Aeruginosa Isolates. Clinical Research and Reports, BioRes Scientia Publishers. 5(1):1-9. DOI: 10.59657/2995-6064.brs.26.055
Copyright: © 2026 Ali S. Shati, this is an open-access article distributed under the terms of the Creative Commons Attribution License, which permits unrestricted use, distribution, and reproduction in any medium, provided the original author and source are credited.
Received: March 28, 2025 | Accepted: September 05, 2025 | Published: January 09, 2026
Abstract
This study was designed to production of zinc oxide nanoparticles, and to determining of minimum inhipetory concentration (MIC) against p. aeruginosa isolates The green method was used in manufacturing zinc oxide nanoparticles with clove extract; 0.5 g zinc chloride was added to 10 ml clove extract, then incubated with a shaker overnight at 25 ºC. The supernatants were centrifuged at 8000 rpm for 20 m. zinc oxide nanoparticle products were characterised using qualitative and quantitative tests. Morphological observation of the supernatants colour change was made after adding zinc chloride colour change into dark brown and light brown, respectively, was the first indicator. The colour of the supernatant was changed. The optimum condition for ZnO biosynthesis was characterised through several techniques such as UV-Vis, AFM, EDX, FT-IR, and FE-SEM. In particular, a cut-off phenomenon of the green synthesised ZnO was found at around 280 nm using UV-Vis, while spherical shape particles were noticed using FE-SEM techniques. Also, the AFM analysis revealed that ZnO NPs have an average diameter size of 45.02 nm. The green synthesized ZnO NPs exhibited a minimum inhibition concentration (3.125 µg/ml) against P. aeruginosa isolates. These results suggest that green synthesized ZnO NPs have a strong inhibitory effect on P. aeruginosa isolates.
Keywords: p. aeruginosa; nanoparticle; burn infection; zinc oxide
Introduction
P. aeruginosa harbors numerous virulence factors, including flagella, pili, and lipopolysaccharides (LPS), aiding in host adhesion and colonization [1 2]. Additionally, it produces tissue damage causative, proteases and toxins, to deliver effectors and toxins into the host secretion systems utilizes, and employs biofilm formation and quorum sensing to communicate and resist antimicrobial therapies [3 4]. Nanotechnology is a scientific discipline that focuses on the manufacture, manipulation, and application of materials at the nanoscale. The term nano originates from the Greek noun "nano," which translates to "dwarf." The particle size of nanoparticles (NP) in medicine varies from 5 to 250 nm [5]. Nanotechnology involves the fabrication of nanomaterials characterized by nanoscale dimensions and distinct, yet regulated, geometries. It addresses their chemical composition and the associated human advantages [6]. The utilization of microorganisms, plant biomass, or plant extracts for nanoparticle synthesis has garnered significant interest in recent years [7]. According to Puri et al (2024) [8], plant-based approaches are more environmentally friendly than conventional physical and chemical methods. Historically, plants hold a crucial role in medicine. For an extended period, plant components have been utilized as crude extracts, decoctions, or combinations for the treatment of various illnesses [9]. Plants have demonstrated a wide-ranging antibacterial efficacy against pathogenic microorganisms [10]. Plants remain potential sources for novel pharmaceuticals and compounds extracted from different plant components [11 12]. Zinc Oxide (ZnO) is an affordable inorganic nanoparticle characterized by straightforward manufacturing processes, a broad spectrum of applications, and safety as a material [13]. Zinc Oxide garners significant interest among academics due to its characteristics [14]. Zinc Oxide is essential in daily life and ranks third in global manufacturing volume, surpassed only by Selenium Oxide (SiO2) and Titanium Oxide (TiO2) among the safest metals for usage [15]. Recent research indicate that Zinc Oxide nanoparticles may be hazardous to bacteria while demonstrating negligible impact on human cells. The biocompatibility of Zinc Oxide nanoparticles is attributed to their particle size, shape, aspect ratio, and morphology [16, 17].
Zinc oxide nanoparticles are environmentally benign and possess biodegradability characteristics. Zinc oxide nanoparticles possess a high surface area to volume ratio, enhancing their solubility and bacterial penetration, hence exhibiting significant antibacterial properties. The antibacterial efficacy of Zinc Oxide nanoparticles primarily derives from the nanoparticles themselves, rather than the minimal release of free Zn 2+ ions. The antibacterial efficacy of Zinc Oxide nanoparticles has been demonstrated in numerous research [18, 19]. Syzygium aromaticum, popularly referred to as clove, is a medium-sized tree (8-12 m) belongs to the Myrtaceae family, indigenous to the Maluku Islands in eastern Indonesia [20]. The clove trade has significantly contributed to the economic prosperity of this region for many years [21]. Eugenol is the primary bioactive ingredient in clove, present in quantities between 9,381.70 and 14,650.00 mg per 100 g of fresh plant material [22]. The antibacterial properties of clove have been demonstrated against several bacterial and fungal species [23]. Sofia et al. evaluated the antibacterial efficacy of various Indian spice plants, including mint, cinnamon, mustard, ginger, garlic, and clove. The sole sample exhibiting a complete bactericidal action against all tested pathogens, including Escherichia coli, Staphylococcus aureus, and Bacillus cereus, was the 3% aqueous extract of clove. At a concentration of 1%, clove extract demonstrated significant inhibitory activity [24]. Clove is a significant and esteemed spice globally. It is an unopened floral bud developing on a tree. Cloves (Syzygium aromaticum Linn.) are the desiccated floral buds with a distinctive perfume. Clove exhibits antioxidant, antifungal, antiviral, antibacterial, antidiabetic, anti-inflammatory, antithrombotic, anesthetic, analgesic, and insect repellent effects [25]. The manufacture of zinc oxide nanoparticles was studied using analytical techniques such as UV-visible spectroscopy and EDX, along with imaging techniques like FE-SEM and AFM. The UV-Visible absorption scan of the supernatant infused with zinc chloride exhibited a peak at 450 nm, signifying the surface plasmon resonance (SPR) of zinc oxide nanoparticles. The TEM picture demonstrated the creation of well-defined ZnO nanoparticles measuring 20-50 nm [26, 27].
Materials and Methods
Bacterial Isolates Collection
For four months from October 2023 to January 2024, one hundred and forty clinical specimens were grabbed from hospitalized patients at the seven general Hospital in Baghdad City, Iraq. These isolates were obtained from both genders and varying ages of patients. Then, the samples were transferred to the lab. As part of the sampling method, from clinically deep burn wound sites that showed clinical symptoms of wound infection after changing the wound Bandage, swaps were taken, and other source such as wound, sputum, ear swap and urinary tract infection. By bacterial cultures (on nutrient agar and MacConkey agar) subculture on Cetrimide agar which is selective media the isolates were determined to be P. aeruginosa according to previous studies, these pure colonies were identified based on their Cultural characteristics. In addition, VITEK-2 system was used to identify P. aeruginosa isolates.
Bacterial DNA Extraction from P. aeruginosa
For two months from October to December 2023, fifty clinical specimens were grabbed from burns hospitalized patients at the general Hospitals in Baghdad City, Iraq. These isolates were obtained from both genders and varying ages of patients. Then, the samples were transferred to the lab. As part of the sampling method, from clinically deep burn wound sites that showed clinical symptoms of wound infection after changing the wound Bandage, swaps were taken, by bacterial cultures on nutrient agar and MacConkey agar subculture which is selective media the isolates were determined to be P. aeruginosa according to previous studies, these pure colonies were identified based on their Cultural characteristics. In addition, VITEK-2 system was used to identify P. aeruginosa isolates.
Preparation of aqueous extract of Syzygium aromaticum buds
The plant material i.e., clove (Syzygium aromaticum Linn.) buds was purchased from the local market in Baghdad. Clove aqueous extract was produced by bringing Fifty gram powdered clove buds and 400 mL of distilled water to a boil for 20 min. The resulting extract was fltered through Whatman No. 1 flter paper and stored at 4 °C for further experiments [28].
Preparation of zinc oxide nanoparticles
The experiment was conducted in the Nanotechnology Laboratory - Department of Plant Biotechnologies, College of Science - University of Baghdad, for every 10ml of Aqueous extract of clove plant, 0.5 gm of zinc chloride (ZnCl2) was added, as it changed its color to a dark color, which is evidence of the transformation into nanoparticles The mixture was placed on the shaker overnight and placed in a centrifuge to precipitate the nanoparticles. The precipitate representing the zinc oxide nanometal was taken and collected in dishes and placed in Oven at 50°C to dry [29, 30].
Results and Discussion
Isolation and identification of P. aeruginosa
The results showed that from a total of 50 specimens, only 34 (72.8%) were clinical positive growth samples, while the rest 16 (27.14 %) were negative growth samples. negative growth results may suggest to absence of infection at the time of sample collection or successful treatment of infection, some organisms may not grow easily in standard lab conditions. Depending on the conventional culture method, and morphological trait, biochemical and microscopic examination found that 13 isolate was p. aeruginosa while the rest 21 (27.14%) samples were other bacterial isolates. Eaight isolates wich high resist to antibiotic accordinf to vitek 2 system test.
Figure 1: This is a figure of p. aeruginosa on MacConkey agar
VITEC-2 test
Fifty isolate (35.71%) from positive growth were identified as p. aeruginosa by culturing on selective medium such as MacConkey agar, cetrimide agar and some biochemical tests as well as VITEK®2 system as a confirmatory test. the isolates were diagnosed as P. aeruginosa. The VITEK-2 System test was identified the presence of P. aeruginosa in all of 50(100%) sample with 95-99% identity. Additionally, the result of VITEK-2 system test mentioned in figure 2 showed the antibiotic sensitivity of P. aeruginosa isolates which was resist to more than 8 antibiotics.
Figure 2: Results of Vitek2 test for P. aeruginosa
Characterization of silver nanoparticles
Qualitative tests were performed by morphological observation of the color change of clove extract after mixing with zinc chloride. Analytical analysis of nanoparticle was conducted in UV-Visible scanning spectrophotometer (Buck, USA) and FTIR (Testscan Shimadzu FTIR 8000 series). Imaging topography was achieved for burned samples using AFM (Angstrom advanced AA2000) and FE-SEM (INSPECT S50, UK).
Ultraviolet (UV -Vis) Spectra
The optical properties of the nanoparticles were studied exploitation ultraviolet – Visible spectrometer. Figure 3 shows the absorbance of the sample in the nano range at room temperature. It has shown a peak at 220 nm wavelength was thus agreed with [31]. The range of UV for zinc oxide nanoparticles was (200 to 800). band gap energy at 290 nm and 330 nm. The absorption edge around 330 nm corresponds to a band gap of approximately 3.7–3.8 eV, typical for ZnO nanoparticles. That agreed with [32]. In general, the presence of a broad absorption band in UV-V is spectra indicate a degree of heterogeneity in the size and shape distribution of the nanosized ZnO, implying that the sample contains a diverse population of ZnO nanoparticles. This underscores the significance of UV-visible analysis in characterizing nanomaterial [33].
Figure 3: (UV-Vis) spectrum of biosynthesized ZnO nanoparticles
Atomic Force Microscope (AFM)
Atomic force microscopy (AFM) techniques have been supplied and preserve to provide more and more crucial insights into surface morphology, mechanics, and different vital fabric characteristics at the nanoscale. The average particle size is approximately 58.02 nm, indicating the material is in the nanoscale range. Median size: 50% of the particles have a size less than 50.00 nm, highlighting the uniformity of the synthesis process. 10% of particles are below 20.00 nm, while 90% are below 95.00 nm, indicating a moderately narrow size distribution.
The 3D AFM image reveals a granular surface with distinct peaks, indicating the presence of well-formed nanoparticles. The surface roughness is evident, with maximum heights approximately 26.72 nm.
The 2D AFM image provides a clearer view of individual nanoparticles distributed across the surface. This result agreed with [34; 35]. Figure 4 and Figure 5. depicts images of ZnO nanoparticles,
AYg. DiameWeU:58.02 nm <=10% DiameWeU:20.00 nm
<=50% DiameWeU:50.00 nm <=90% DiameWeU:95.00 nm
Figure 4: Average size of ZnO nanoparticles.
Figure 5: Atomic Force Microscopy (AFM) of biosynthesized zinc nanoparticles.
Fourier Transform Infrared Spectroscopy (FTIR)
Fourier transform infrared (FTIR) spectroscopy was employed to examine the synthesized zinc oxide (ZnO) nanoparticles. This technique aims to identify the functional groups present in compounds and determine their molecular structures [36]. The FTIR spectrum displays absorption peaks corresponding to the vibrational modes of these functional groups, enabling the identification of distinctive functional signatures, such as OH, C=O, NH, CH, and others, thus confirming the presence of specific chemical bonds. The FTIR spectra of the synthesized ZnO samples were examined within the wavelength range of 4000–500 cm-1, as shown in figure 4, using the aforementioned method. The absorption peak at (3280 cm-1) is attributed to the O–H bond stretching, while the peak at (2182 cm-1) corresponds to the C-C bond. The absorption band around (1636 cm-1) corresponds to the stretching of Alkenyl C=C. Strong absorption peaks observed in the range of 500-600 cm-1 are indicative of ZnO nanoparticles, specifically denoting the stretching frequency of Zn–O bonds. This observation confirms the presence of a metal oxide compound [37]. Another notable peak at (1058 cm-1) could be linked to secondary alcohols. In terms of comparing the functional groups, the ZnO nanoparticles display distinct absorption features related to their composition, while the basil leaf extract exhibits characteristic peaks corresponding to its unique molecular components, It's worth noting that the functional groups present in the extract contribute electrons, which have the potential to facilitate the reduction of zinc ions (Zn+2 to Zn+1) and ultimately lead to the formation of zinc nanoparticles (ZnO) as in the studies [38, 39].
Figure 6: FTIR spectrum of biosynthesized ZnO nanoparticles.
Field Emission Scanning Electron Microscope (FE-SEM) of ZnO NPs
FESEM pictures were measured and geographics analysis was performed based mostly upon the surface study. are spherical or round with a smooth surface [40]. The images of ZnO NPs, has shown in figure 7,has shown the FESEM pictures of iron compound no particles, confirming that nanoparticles are grownup with well-defined morphology and diameters varied between 20 and 40 nm. [41]. The shape size of the particles varies. That agreed with [42, 43].
Figure 7: FE-SEM image of Zinc Oxide nanoparticles prepared by Syzygium aromaticum extract.
Characterization of ZnO nanoparticles using EDX
The Data in figures 8 shows the EDX spectrum analysis indicated that the gold atoms emitted good signals. At the same time, other elements such as carbon, oxygen, aluminum, zinc, chloride showed weaker signals.
Figure 8: Energy dispersive X-ray of biosynthesized zinc nanoparticles
Minimum Inhibitory and Bacteriostatic Concentration
The obtained results indicate that synthesized ZnO nanoparticles (NPs) possess antibacterial effects against P. aeruginosa isolates. The minimum inhibitory concentration was determined by Resazurin-based turbidimetric assay used to determine the MIC with 96-well flat-bottom microtiter plates. According to the results of the turbidimetric test as shown in Figure 9 a range of concentrations, from (50µg/ml to 0.097µg/ml) of the prepared ZnO NPs from plant extract on Mueller Hinton broth culture media. The green synthesized ZnO NPs exhibited a minimum inhibition concentration (3.125 µg/ml) against P. aeruginosa isolates. These results suggest that green synthesized ZnO NPs have a strong inhibitory effect on P. aeruginosa isolates. A study done by Doğan & Kocabaş, (2019) [44] reported the MIC value of ZnO NPs generated by plant extract of V. multifida against P. aeruginosa isolates ranged from 25- 50 μg/ml.
Figure 9: Flat-bottom microliter plates for determine MIC of synthesized ZnO nanoparticles against P. aeruginosa isolates.
Results
Through the utilization of prodigiosin as a reducing agent, this work successfully demonstrated the creation of zinc oxide nanoparticles from zinc oxide. Further, the ZnO nanoparticles that were generated were examined using a variety of techniques, including UV-Vis, AFM, XRD, FT-IR, and FE-SEM procedures. Both the XRD patterns and the FE-SEM demonstrated that the produced ZnO nanoparticles had both spherical and plate-like geometries, with an average diameter ranging from 30 to 50 nm. The XRD patterns confirmed that the synthesis of ZnO nanoparticles was successful. Using the AFM, it was determined that the average diameter was 45.02 nm. While conducting the evaluation of the antibacterial activity, Despite the higher MIC in the current study, the results highlight the inhibitory potential of green-synthesized ZnO NPs. This underscores their importance in combating multidrug-resistant pathogens like P. aeruginosa.
Declarations
Acknowledgments
We express our gratitude to Al-Nahrain University and the collage of biotechnology, namely the head of the collage, for their consent to proceed with this study. Gratitude is expressed to the researchers who contributed to the successful completion of this study.
Author’s Declaration
We hereby confirm that all the Figures and Tables in the manuscript are original and have been created by us.
We have obtained ethical clearance for our study from the local ethical committee at [Al-Nahrain University/College of Biotechnology]. This approval underscores our commitment to ethical research practices and the well-being of our participants.
Ethical Clearance: The project was approved by the local ethical committee at [Al-Nahrain University/College of Biotechnology], ensuring adherence to ethical standards and the protection of participants' rights and welfare.
Author’s Contribution Statement
[First Author]: Contributed to the conception and design of the study, conducted some experiments, data rearrangement and drafted the initial manuscript.
[Second Author]: conducted some experiments, collection a part of literature review and conducted some characteristics of the products.
References
- Risan, M. H. (2024). Evaluate the prevalence of the Virulence Genes (lptD & lptE) among Pseudomonas aeruginosa isolated from different infectious origins. Iraqi J. Biosci. Biomed, 1:1-11.
Publisher | Google Scholor - Al-yasiri, S., Ürker, O. & Risan, M. H. (2024). Molecular Identification for MEXZ and Aac6 Genes from Pseudomonas Aeruginosa Isolates. 1-6.
Publisher | Google Scholor - Al-Chalabi, F. A., Risan, M. H. & Abed, R. M. Silver Nanoparticles Inhibition of SAP 7 and SAP 9 Gene Expression in Candida albicans Isiolates from Diabetic Foot Ulcers.
Publisher | Google Scholor - Liao, C., Huang, X., Wang, Q., Yao, D. & Lu, W. (2022). Virulence Factors of Pseudomonas Aeruginosa and Antivirulence Strategies to Combat Its Drug Resistance. Front. Cell. Infect. Microbiol, 12:926758.
Publisher | Google Scholor - Leading, L. & Eu, E. U. Exploring the nano-world.
Publisher | Google Scholor - Jagadeesh, P., Rangappa, S. M. & Siengchin, S. (2024). Advanced characterization techniques for nanostructured materials in biomedical applications. Adv. Ind. Eng. Polym. Res, 7:122-143.
Publisher | Google Scholor - Adeyemi, J. O., Oriola, A. O., Onwudiwe, D. C. & Oyedeji, A. O. (2022). Plant Extracts Mediated Metal-Based Nanoparticles: Synthesis and Biological Applications. Biomolecules, 12.
Publisher | Google Scholor - Puri, A. et al. (2024). From nature to nanotechnology: The interplay of traditional medicine, green chemistry, and biogenic metallic phytonanoparticles in modern healthcare innovation and sustainability. Biomed. Pharmacother, 170:116083.
Publisher | Google Scholor - Palombo, E. A. (2011). Traditional Medicinal Plant Extracts and Natural Products with Activity against Oral Bacteria: Potential Application in the Prevention and Treatment of Oral Diseases. Evid. Based. Complement. Alternat. Med, 2011:680354.
Publisher | Google Scholor - Chassagne, F. et al. (2020). A Systematic Review of Plants With Antibacterial Activities: A Taxonomic and Phylogenetic Perspective. Front. Pharmacol, 11:586548.
Publisher | Google Scholor - Hostettmann, K. & Marston, A. (2008). Plants as a still unexploited source of new drugs. Nat. Prod. Commun, 3:1307-1315.
Publisher | Google Scholor - Salah, N. S., Muhsen, T. A. A. & Risan, M. H. (2020). Antifungal activity of silver nanoparticles using Penicillium chrysogenum extract against the formation of biofilm for Candida glabrata. Indian J. Forensic Med. Toxicol, 14:379-384.
Publisher | Google Scholor - Risan, M., Mohsen, B. A. & Ghatea, A. (2023). Green synthesis of ZNO nanoparticles using aloe vera leaves extract. Iraqi J. Nat. Sci. Nanotechnol, 4:93-103.
Publisher | Google Scholor - Kudaer, N. B. et al. (2022). Effect of zinc oxide nanoparticles on capsular gene expression in Klebsiella pneumoniae isolated from clinical samples. Biomimetics, 7:180.
Publisher | Google Scholor - Kudaer, N. B., Yousif, E., Risan, M. H. & Khadom, M. (2022). Preparation of ZnO nanoparticles by the chemical precipitation method. J. Serambi Eng, 7.
Publisher | Google Scholor - Al-darwesh, M. Y., Ibrahim, S. S. & Mohammed, M. A. (2024). A review on plant extract mediated green synthesis of zinc oxide nanoparticles and their biomedical applications. Results Chem, 7:101368.
Publisher | Google Scholor - Ahmed, D. S. et al. (2019). Green synthesis of silver nanoparticles by plants extract. Int. J. Chem. Process Eng. Res, 6,1-6.
Publisher | Google Scholor - Zhou, X.Q., Hayat, Z., Zhang, D.D., Li, M.Y., Hu, S., Wu, Q., Cao, Y.F., Yuan, Y. (2023). Modification, and applications in food and agriculture. Processes, 11:1193.
Publisher | Google Scholor - Al-yasiri, S., Ürker, O. & Risan, M. H. (2024). Activity of AG NPS Silver Nanoparticles Aloe Vera Plant Against Pseudomonas Aeruginosa. 1-4.
Publisher | Google Scholor - Cortés-Rojas, D. F., de Souza, C. R. F. & Oliveira, W. P. (2014). Clove (Syzygium aromaticum): a precious spice. Asian Pac. J. Trop. Biomed, 4:90-96.
Publisher | Google Scholor - Andrianandrasana, H. T., Campera, M., Viraina, F. F., Long, P. R. & Jones, N. (2024). Additional measures needed to ensure clove industry does not contribute to tree cover loss in Madagascar. For. Policy Econ, 169:103333.
Publisher | Google Scholor - Idowu, S., Adekoya, A., Igiehon, O. & Idowu, A. (2021). Clove (Syzygium aromaticum) spices: a review on their bioactivities, current use, and potential application in dairy products. J. Food Meas. Charact,15:1-17.
Publisher | Google Scholor - Yaqub, M. (2024). Antimicrobial activity of clove extract [2070].
Publisher | Google Scholor - Maharjan, R., Thapa, S. & Acharya, A. (2019). Evaluation of Antimicrobial Activity and Synergistic Effect of Spices against Few Selected Pathogens [Evaluación de la actividad antimicrobiana y el efecto sinérgico de las especias frentea unos pocos patógenos seleccionados]. Tribhuvan Univ. J. Microbiol, 6:10-18.
Publisher | Google Scholor - Batiha, G. E.-S. et al. Syzygium aromaticum L. (2020). (Myrtaceae): Traditional Uses, Bioactive Chemical Constituents, Pharmacological and Toxicological Activities. Biomolecules, 10.
Publisher | Google Scholor - Jayachandran, A., T R, A. & Nair, A. S. (2021). Green synthesis and characterization of zinc oxide nanoparticles using Cayratia pedata leaf extract. Biochem. Biophys. Reports, 26:100995.
Publisher | Google Scholor - Hassan, Z. A. & Risan, M. H. (2024). Green synthesis of zinc oxide nanoparticles and its antibacterial Activity on Pseudomonas aeruginosa. J. Biotechnol. Res. Cent, 18.
Publisher | Google Scholor - Lakhan, M. N. et al. (2020). Eco-friendly green synthesis of clove buds extract functionalized silver nanoparticles and evaluation of antibacterial and antidiatom activity. J. Microbiol Methods, 173:105934.
Publisher | Google Scholor - Nawar, M. H., Yaaqoob, L. A., Hatem, M. waleed & Mohammed, A. K. (2024). The Effect of Nanoparticles Preparation from Extract Of DodonaeaViscosaL. Leaves on the Biological Performance of The Great Waxworm. AIP Conf. Proc, 2922.
Publisher | Google Scholor - Mohammed, T. H., Risan, M. H. & Yousif, E. (2019). Biosynthesis of silver nanoparticles using Aspergillus terreus. Biochem. Cell. Arch, 19:4225-4229.
Publisher | Google Scholor - AdibAmini, S., Sari, A. H. & Dorranian, D. (2023). Optical properties of synthesized Au/Ag Nanoparticles using 532 nm and 1064 nm pulsed laser ablation: effect of solution concentration. SN Appl. Sci, 5:122.
Publisher | Google Scholor - Khan, S. B., Faisal, M., Rahman, M. M. & Jamal, A. (2011). Low-temperature growth of ZnO nanoparticles: Photocatalyst and acetone sensor. Talanta, 85:943-949.
Publisher | Google Scholor - Al-Zahrani, S. A., Khedr, A. M., Alturki, A. M. & Abo El-Yazeed, W. S. (2024). Integration of 2D graphene oxide/zinc oxide nanohybrid for enhancement adsorption and photodegradation of organic pollutants. J. Mol. Liq, 395:123956.
Publisher | Google Scholor - Fadhil, F. & Hadi, I. (2015). Preparation and characterization of zinc oxide nanoparticles by laser ablation of zinc in isopropanol. Eng. Technol. J, 33:791-798.
Publisher | Google Scholor - Saadi, M. A. S. R., Uluutku, B., Parvini, C. H. & Solares, S. D. (2020). Soft sample deformation, damage and induced electromechanical property changes in contact- and tapping-mode atomic force microscopy. Surf. Topogr. Metrol. Prop, 8:45004.
Publisher | Google Scholor - Dejen, K. D., Zereffa, E. A., Murthy, H. C. A. & Merga, A. (2020). Synthesis of ZnO and ZnO/PVA nanocomposite using aqueous Moringa Oleifeira leaf extract template: antibacterial and electrochemical activities. 59:464-47.
Publisher | Google Scholor - Mankad, M., Patil, G., Patel, S., Patel, D. & Patel, A. (2016). Green synthesis of zinc oxide nanoparticles using Azadirachta indica A. Juss. leaves extract and its antibacterial activity against Xanthomonas orzyae pv. oryzae. Ann. Phytomedicine An Int. J, 5:76-86
Publisher | Google Scholor - Resmi, R., Yoonus, J. & Beena, B. (2021). A novel greener synthesis of ZnO nanoparticles from Nilgiriantusciliantus leaf extract and evaluation of its biomedical applications. Mater. Today Proc, 46:3062-3068.
Publisher | Google Scholor - Alamdari, S. et al. (2020). Preparation and Characterization of Zinc Oxide Nanoparticles Using Leaf Extract of Sambucus ebulus. Appl. Sci, 10:1-19.
Publisher | Google Scholor - Mahadik, S. A. & Mahadik, S. S. (2021). Surface morphological and topographical analysis of multifunctional superhydrophobic sol-gel coatings. Ceram. Int, 47:29475-29482.
Publisher | Google Scholor - Parveen, S. et al. (2018). Preparation, characterization and antifungal activity of iron oxide nanoparticles. Microb. Pathog, 115:287-292.
Publisher | Google Scholor - Naz, F., Kumar Dinda, A., Kumar, A. & Koul, V. (2019). Investigation of ultrafine gold nanoparticles (AuNPs) based nano formulation as single conjugates target delivery for improved methotrexate chemotherapy in breast cancer. Int. J. Pharm, 569:118561.
Publisher | Google Scholor - Mohammad, T. H., Risan, M. H., El-Hiti, G. A., Ahmed, D. S. & Yousif, E. (2020). Successful in-vivo treatment of mice infected with Candida glabrata using silver nanoparticles. Rev. Bionatura, 5:1340-1345.
Publisher | Google Scholor - Doğan, S. Ş. & Kocabaş, A. (2019). Green synthesis of ZnO nanoparticles with Veronica multifida and their antibiofilm activity. Hum. Exp. Toxicol, 39:319-327.
Publisher | Google Scholor